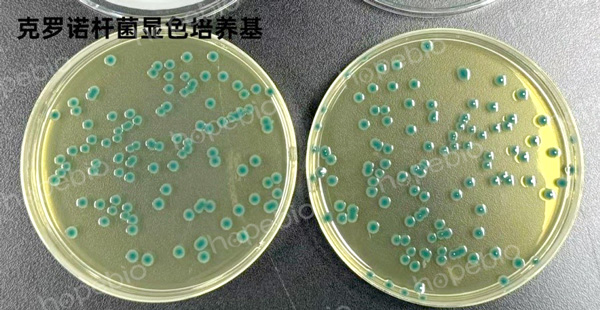

海博微信公众号
海博微信公众号
 海博天猫旗舰店
海博天猫旗舰店


 海博微信公众号
海博微信公众号
 海博天猫旗舰店
海博天猫旗舰店




克罗诺杆菌,原名阪崎肠杆菌,是一种食源性致病菌。它广泛存在于自然环境中,如土壤、水、植物根茎等,但最受关注的是它能引起婴儿,特别是新生儿和2个月以下婴儿的严重甚至致命的感染。
其主要危害为引起婴儿败血症、坏死性小肠结肠炎和脑膜炎。其中,脑膜炎可能导致严重的神经系统后遗症(如脑脓肿、脑室炎、发育障碍等),死亡率高达40%-80%。婴儿配方奶粉是其最受关注的传播途径。克罗诺杆菌在干燥环境下生存能力强,可在奶粉生产环节中(如原料、加工环境)存在,并污染终产品。
现根据GB4789.40-2024克罗诺杆菌检验,详细描述一下其定性检验过程

图一:克罗诺杆菌检验程序
1、 前増菌和选择性増菌
取100g(mL)样品置于无菌容器内,加入已经预热至41℃±1℃的900mL BPW中,缓慢摇动至充分溶解,36℃±1℃培养18h±2h。轻轻晃动混匀培养液,取1mL至10mL mLST-Vm肉汤中,41.5℃±1℃培养24h±2h。

图二:mLST-Vm肉汤培养基41.5℃±1℃培养24h±2h后。
2、 分离培养
轻轻混匀mLST-Vm肉汤培养物,使用10ul接种环各取1环増菌培养物,分别划线接种于2个克罗诺杆菌显色培养基平板36℃±1℃培养24h±2h,挑取克罗诺杆菌上生长的蓝绿色可疑菌落,每个平板挑取至少5个可疑菌落(不足5个时挑取全部可疑菌落),分别划线于TSA平板36℃±1℃培养24h±2h。
图三:克罗诺杆菌在克罗诺杆菌显色培养基上的特征性反应
3、 PCR鉴定(选做)
4、 确证试验
未选做PCR时,将接种于TSA的可疑菌落进行生化鉴定,主要特征见下表

图四:克罗诺杆菌主要生化特征

图五:克罗诺杆菌生化特征
相关产品:
改良月桂基硫酸盐胰蛋白胨肉汤-万古霉素(mLST-Vm)-点击查看产品详情
注:本文属海博生物原创,未经允许不得转载。
上一篇:细菌的“糖谱”与显色反应
下一篇:酿酒酵母在生活中的应用
| 相关文章: | ||



